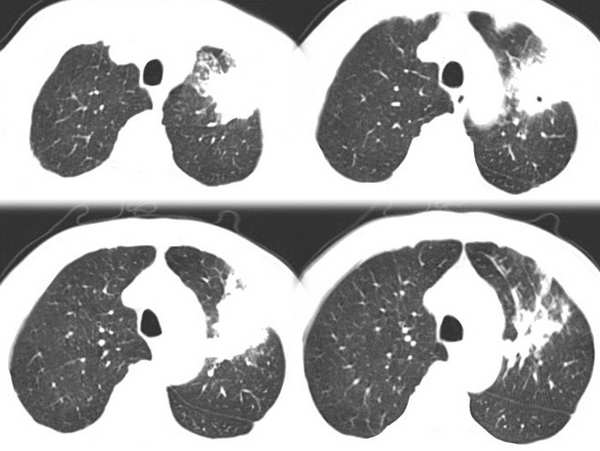

医影在线
标题: CT2895:胸部,请各位老师发表高见!!!! [打印本页]
作者: 医博云天 时间: 2006-3-3 03:14
标题: CT2895:胸部,请各位老师发表高见!!!!
男,58岁,咳嗽1月加重1周,伴痰中带血

[本贴已被 jiajie 于 2006-3-2 19:43:41 修改过]
[本贴已被 翁志蓬 于 2006-3-2 20:24:25 修改过]
作者: 扬仪 时间: 2006-3-3 03:21
谢谢 优质图片
支持肺ca!
作者: lvlifeng 时间: 2006-3-3 03:39
肺癌
作者: yang123456 时间: 2006-3-3 03:41
考虑肺癌。
作者: wxh369 时间: 2006-3-3 03:43
肺癌
作者: xiaoniu 时间: 2006-3-3 03:48
左肺上叶胸膜下不规则团块阴影,内见空泡,边缘光整,肺纵比率>50%,支持左肺癌的诊断。
作者: 绿水青山 时间: 2006-3-3 03:56
ct:左上肺块状影、其内徐点状气体外蜜度大致均匀。周围粗大索状影
临床:59岁、瘘中带血
诊断1左上肺癌?2肺结核?建议痰检、穿刺活检
作者: 我爱放射 时间: 2006-3-3 03:59
肺癌
作者: xjw755499 时间: 2006-3-3 04:02
肺癌
作者: 摆哥 时间: 2006-3-3 04:03
其内透光影仔细观察像是支气管,病灶周围有渗出改变,该病灶不考虑感染性病变,机化性肺炎能排除吗
作者: SHUQIANG1 时间: 2006-3-3 04:23
临床表现结合ct定位像看更支持肺结核,慢性机化肺炎也要考虑,高年龄更要注意肺癌存在.
作者: mmg94 时间: 2006-3-3 04:41
慢性肺炎可能性大喔。
作者: liuyongbinking 时间: 2006-3-3 04:59
支持肺癌
作者: chinaboy_006 时间: 2006-3-3 05:05
首先考虑结核,其次是肺癌,建议穿刺活检
作者: huangaiying1 时间: 2006-3-3 05:18
首先考虑左侧周围型肺癌
理由:1 病灶有恶性肿瘤的特征:空泡征,毛刺,棘状突起
2 痰中带血
作者: 同 时间: 2006-3-3 05:37
支持肺癌
作者: 中山医 时间: 2006-3-3 05:50
标题: 回复:ct2895:胸部,请各位老师发表高见!!!!
以下是引用chinaboy_006在2006-3-2 21:05:00的发言:[br]首先考虑结核,其次是肺癌,建议穿刺活检
作者: wxy7406 时间: 2006-3-3 05:50
首先考虑肺结核.结核好发部位,下面几幅图像不是很支持肿块.
作者: caihe 时间: 2006-3-3 06:01
左上肺病灶与胸膜脂肪线存在,未见明显胸膜凹陷征,虽然病灶边缘不规则,但未见明显“短毛剌、切迹征、免耳征、血管束集征”,其间亦见条索状、斑点状影,认为左上肺结核或炎性病变>周围型肺癌。
作者: 海比天蓝 时间: 2006-3-3 06:09
我和10楼,想的一样,请各位老师指教,
作者: 3288161 时间: 2006-3-3 06:16
肺结核可能性大
作者: JQKA910 时间: 2006-3-3 06:29
ct:左上肺块状影、其内徐点状气体外蜜度大致均匀。周围粗大索状,肺结核.
作者: ssl1_1 时间: 2006-3-3 06:31
考虑肺癌
作者: aosangwa 时间: 2006-3-3 06:36
支持肺癌(周围型肺癌)
作者: GDSZF 时间: 2006-3-3 14:57
肺病结核可能性较大?
作者: kbzyycm 时间: 2006-3-3 15:29
考虑肺癌
作者: chen123 时间: 2006-3-3 16:25
首先考虑肺结核 待除外肺癌
作者: zhuxinli 时间: 2006-3-3 17:15
病灶比较虚 周围有明显渗出 卫星灶及条素影 病灶边缘有棘突 胸膜外脂肪层存在考虑结核
作者: liaoqiang 时间: 2006-3-3 17:16
考虑肺结核可能性大。理由1.病灶形态不规则,其周有卫星灶,2.病灶没有毛刺征,灶周出现粗大索条影.
作者: 郭凯 时间: 2006-3-3 17:47
标题: 回复:ct2895:胸部,请各位老师发表高见!!!!
以下是引用huangaiying1在2006-3-2 21:18:00的发言:[br]首先考虑左侧周围型肺癌[br]理由:1 病灶有恶性肿瘤的特征:空泡征,毛刺,棘状突起[br] 2 痰中带血
请问病人临床资料,有无发热症状?
作者: duguo 时间: 2006-3-3 18:21
肺泡癌?
作者: ygdygd123a 时间: 2006-3-3 18:23
1肺结核,2肺癌
作者: lnjz4545wq 时间: 2006-3-3 21:48
首先考虑肺结核
作者: 东北 时间: 2006-3-4 00:50
肺癌
作者: 云中燕 时间: 2006-3-4 17:10
先做结核菌素实验,然后查痰细胞和痰菌,然后结合ct片在下结论.
作者: yinpeihu2003 时间: 2006-3-4 17:15
做结核菌素实验,然后查痰细胞和痰菌,做mr,然后综合判断一下。
作者: 医博云天 时间: 2006-7-29 20:03
谢谢各位关注!@
作者: shibing 时间: 2015-6-2 14:46
肺癌
| 欢迎光临 医影在线 (http://bbs.radida.com/bbs/) |
Powered by Discuz! X3.2 |